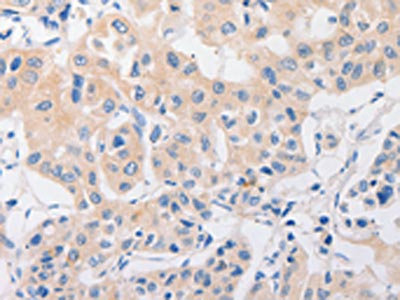

P2RY11 Antibody
-
中文名稱:P2RY11兔多克隆抗體
-
貨號(hào):CSB-PA139014
-
規(guī)格:¥1100
-
圖片:
-
The image on the left is immunohistochemistry of paraffin-embedded Human ovarian cancer tissue using CSB-PA139014(P2RY11 Antibody) at dilution 1/30, on the right is treated with synthetic peptide. (Original magnification: ×200)
-
The image on the left is immunohistochemistry of paraffin-embedded Human lung cancer tissue using CSB-PA139014(P2RY11 Antibody) at dilution 1/30, on the right is treated with synthetic peptide. (Original magnification: ×200)
-
Gel: 10%SDS-PAGE, Lysate: 40 μg, Lane: Mouse liver tissue, Primary antibody: CSB-PA139014(P2RY11 Antibody) at dilution 1/450, Secondary antibody: Goat anti rabbit IgG at 1/8000 dilution, Exposure time: 1 minute
-
-
其他:
產(chǎn)品詳情
-
Uniprot No.:
-
基因名:
-
別名:P2RY11; P2Y purinoceptor 11; P2Y11
-
宿主:Rabbit
-
反應(yīng)種屬:Human,Mouse
-
免疫原:Synthetic peptide of Human P2RY11
-
免疫原種屬:Homo sapiens (Human)
-
標(biāo)記方式:Non-conjugated
-
抗體亞型:IgG
-
純化方式:Antigen affinity purification
-
濃度:It differs from different batches. Please contact us to confirm it.
-
保存緩沖液:-20°C, pH7.4 PBS, 0.05% NaN3, 40% Glycerol
-
產(chǎn)品提供形式:Liquid
-
應(yīng)用范圍:ELISA,WB,IHC
-
推薦稀釋比:
Application Recommended Dilution ELISA 1:1000-1:5000 WB 1:200-1:1000 IHC 1:50-1:200 -
Protocols:
-
儲(chǔ)存條件:Upon receipt, store at -20°C or -80°C. Avoid repeated freeze.
-
貨期:Basically, we can dispatch the products out in 1-3 working days after receiving your orders. Delivery time maybe differs from different purchasing way or location, please kindly consult your local distributors for specific delivery time.
-
用途:For Research Use Only. Not for use in diagnostic or therapeutic procedures.
相關(guān)產(chǎn)品
靶點(diǎn)詳情
-
功能:Receptor for ATP and ADP coupled to G-proteins that activate both phosphatidylinositol-calcium and adenylyl cyclase second messenger systems. Not activated by UTP or UDP.
-
基因功能參考文獻(xiàn):
- these results show hepatocellular carcinoma-specific expression of the P2Y11 receptor and its critical role in mediating ATP-inducing Ca2+ signalling and regulating cancer cell migration PMID: 28418839
- Decreased P2Y11 signaling plays an important role in the development of narcolepsy with cataplexy. PMID: 28460015
- Hypoxia/reoxygenation inhibits P2y11 receptor expression and its immunosuppressive activity in human dendritic cells. PMID: 26078273
- Suggest role for LXA4 in stimulating apical ATP secretion via pannexin-1 channels and P2RY11 purinoreceptors activation leading to an airway surface liquid layer height increase and epithelial repair. PMID: 24588705
- vesicular exocytosis of ATP and autocrine, positive feedback through P2Y11 receptors is required for the effective activation of macrophages PMID: 23577075
- P2Y11 receptor mediates interferon gamma-induced IL-6 production in HaCaT cells, suggesting the importance of purinergic signaling in interferon-gamma induced skin inflammatory conditions PMID: 23461851
- P2Y11 receptors are abundantly and diffusely expressed intracellularly in skeletal muscle fibers. PMID: 22052557
- The study extends on the observation of a strong multiethnic association of polymorphisms in the TCRA and P2RY11 with narcolepsy, but does not confirm the association of CPT1B/CHKB (rs5770917) in the Chinese population. PMID: 22177342
- Extracellular NAD stimulates mesenchymal stem cell functions through activation of P2Y11 receptor. PMID: 20964598
- Common variants in P2RY11 are associated with narcolepsy. PMID: 21170044
- Inhibition of Natural killer cell response to CX3CL1 is mediated by the P2Y11 receptor. PMID: 20668227
- beta-NAD(e)+ is an agonist of the P2Y(11) purinoceptor and P2Y(11) is the endogenous receptor in granulocytes mediating the sustained [Ca2+]i increase responsible for their functional activatio PMID: 16926152
- We propose that residues Arg106, Arg268, Arg307 and Glu186 are involved in ionic interactions with the phosphate moiety of ATP. Arg307 is possibly also H-bonded to N6 of ATP via the backbone carbonyl. PMID: 17338680
- In human granulocytes, endogenous P2Y(11) proved to be responsible for NAADP+-induced cell activation, unveiling a role of NAADP+ as a pro-inflammatory cytokine. PMID: 17707504
- The P2 receptor mediating the antiapoptotic actions of ATP was identified using a combination of more selective ATP analogs, receptor expression studies, and study of downstream signaling pathways. PMID: 18056402
- present data clearly show that P2Y purinoceptor 11 and P2Y purinoceptor 12 are expressed in human pancreatic islets PMID: 18726826
顯示更多
收起更多
-
亞細(xì)胞定位:Cell membrane; Multi-pass membrane protein.
-
蛋白家族:G-protein coupled receptor 1 family
-
組織特異性:Highest expression in liver and spleen.
-
數(shù)據(jù)庫(kù)鏈接:
Most popular with customers
-
-
YWHAB Recombinant Monoclonal Antibody
Applications: ELISA, WB, IHC, IF, FC
Species Reactivity: Human, Mouse, Rat
-
Phospho-YAP1 (S127) Recombinant Monoclonal Antibody
Applications: ELISA, WB, IHC
Species Reactivity: Human
-
-
-
-
-